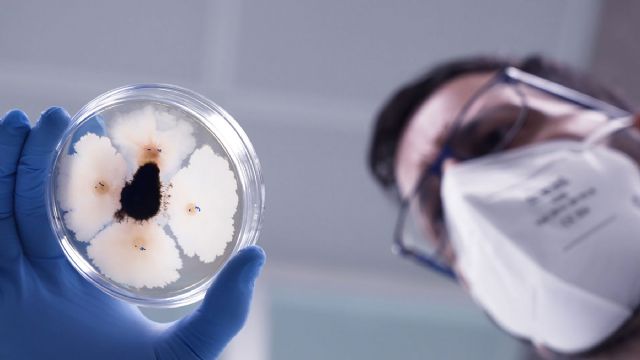
La importancia de la investigación en las empresas biotecnológicas - 3, Foto 3

Inmersos en la búsqueda de una agricultura sostenible, nos encontramos en un periodo de transición con grandes retos a los que hay que ir dando respuestas eficaces y con celeridad.
Un periodo necesario también de convivencia entre técnicas e insumos tradicionales y de innovación para la producción agrícola, tanto para consumo humano como ganadero. Los primeros deben ir desplazándose, como por ejemplo productos químicos, por otros de última generación más respetuosos con el medioambiente y además funcionales y sostenibles.
Como todo ello afecta a toda la cadena de valor, para ser objetivos, en esta ocasión nos vamos a centrar en el sector de la fabricación de productos fertilizantes y fitosanitarios, vitales para el cultivo.
¿Cómo trabaja un departamento de I+D+i en una empresa biotecnológica? ¿Cómo se conforma su equipo humano? ¿Cuáles son las principales líneas de investigación? ¿Cómo es el proceso? ¿Cuánto se tarda en conseguir resultados? etc., son preguntas que damos respuesta de la mano de Pedro R. Molina Guevara, Director del Departamento de Investigación, Desarrollo e Innovación, de la firma Probelte, empresa asociada a AEFA.
Pedro R. Molina es investigador senior y Doctorado en Ciencias, cuenta con más de 20 años de experiencia y una amplia formación en biotecnología agrícola tanto en instituciones académicas como en empresas privadas.
Durante esta última década, ha trabajado en el ámbito del desarrollo de bioestimulantes y biofertilizantes innovadores a partir de fuentes microbianas.
Entre sus principales competencias se encuentran la gestión de proyectos de investigación, biotecnología vegetal, agricultura, OMG, genética vegetal, bioquímica, microbiología, fermentación, biología molecular, bioestimulantes y biofertilizantes.
¿Cómo trabaja un departamento de I+D+i en una empresa biotecnológica?
El trabajo de este tipo de departamento, generalmente se organiza en base a los planes actuales de desarrollo de la empresa. A partir de ahí, se integran varios departamentos para abordar las necesidades, y con un trabajo en equipo integrado, transversal y engranado poder elaborar los proyectos. Esta es la fórmula que garantiza el éxito de los proyectos de investigación y desarrollo de productos.
Aunque puede parecer obvio, es muy importante remarcar que, aunque los proyectos sean liderados por el departamento de I+D+i, no es algo que se hace solamente en y desde el laboratorio. La participación de otros departamentos es crucial.
Por ejemplo, el departamento de I+D+i se integra aportando su conocimiento y experiencia para abordar los retos planteados. Las investigaciones que se realizan en él son importantes para poder argumentar mediante ensayos y experimentos las capacidades, bondades, características, efectividad, etc. de cada uno de los productos que se desarrollan.
Solamente, mediante este conocimiento del producto, que nos permite demostrar científicamente su funcionamiento, podemos convencer al usuario final con datos y no con opiniones.
En este contexto ¿Cuál es el protocolo de desarrollo de un producto biotecnológico?
El desarrollo de un producto biotecnológico comienza por discutir primero las ideas que surgen en el equipo en base a las necesidades que se quieren cubrir o resolver. A partir de ahí se planifica el proyecto considerando todos los recursos necesarios: fungibles, colaboraciones, personal, tiempo, etc.
El siguiente paso es obtener la, o cepas, necesarias para el desarrollo del producto biológico, que puede hacerse a partir del aislamiento de cepas del suelo o de plantas en el campo si fuese necesario, o también partir de centros de colección de cepas.
A la cepa se le realizan entonces evaluaciones para definir sus características, potencial para el éxito del objetivo planteado con este producto en concreto, caracterización de metabolitos y sus interacciones, estudio de sus condiciones de reproducción a escala de laboratorio, su viabilidad, etc.
De ahí se pasa al escalado piloto para su producción (fermentadores de 30 litros, por ejemplo), estudios de formulación, ensayos de actividad biológica en condiciones controladas (invernaderos o cámaras de crecimiento) y selección de los cultivos para los ensayos, dependiendo de las necesidades para el potencial Registro.
Seguidamente se realizan los ensayos preliminares en campo para el Registro con el objetivo de confirmar el efecto deseado. Posteriormente se inicia el proceso de Registro, que depende de si el producto será registrado como un biocontrol o como fertilizante/bioestimulante. Y finalmente se comienza su comercialización después de tener el Registro, donde se especifica cómo debe usarse, dosis, tipo de cultivo donde se puede usar: hortícolas, leñosos, cereales, etc.
Por supuesto, también entra en escena el departamento de marketing para su promoción y comunicación al sector. Así como los equipos de técnicos comerciales para transferir esta tecnología al tejido productor.
¿Cómo se conforma el equipo humano de un departamento de I+D+i?
Para situarnos, partimos de la base de empresas de fabricación de productos biofertilizantes y biofitosanitarios. Aun así, la respuesta es compleja porque también intervienen factores como el nivel de apuesta por parte de la empresa en cuestión, recursos económicos, interés de mercado final, etc.
Pero quiero dar una respuesta que se ajuste a la realizad, y como este departamento es estratégico para muchas empresas, para no desvelar una posible información de terceros, me ceñiré a nuestro caso.
El equipo de I+D+i de Probelte está formado por siete personas. De este total, el 43% son doctores en Ciencia y destacar que el 57% del Departamento son mujeres. En este grupo contamos con especialistas en diversas áreas como biología molecular, fitopatología, entomología, química, bioquímica, microbiología, etc.
Además del personal fijo del Departamento, todos los años recibimos estudiantes de la Universidad y de centros FP. Además de participar en su formación, estos estudiantes aportan su ayuda a la empresa y constituyen una cantera de la cual nos hemos nutrido a veces. De hecho, dos de los técnicos del Departamento, estuvieron realizando sus prácticas con nosotros.
También es importante comentar la importancia de la colaboración que tenemos con centros tecnológicos y Universidades. Esto nos permite abordar algunas investigaciones básicas necesarias pero que la empresa no puede abordar por equipamiento, infraestructuras o conocimiento. Por ejemplo, en 2023 terminamos un proyecto para la secuenciación completa del genoma de nuestras cepas más importantes con el grupo de investigación Biotecnología Microbiana, perteneciente al Departamento de Genética y Microbiología de la Facultad de Biología de la Universidad de Murcia, bajo la dirección del Doctor Antonio Sánchez Amat.
En este contexto ¿Cuáles son las principales líneas de investigación de un de I+D+i?
Volvemos al punto de partida anterior, donde cada empresa tiene sus estrategias, por lo que dar una respuesta general carece de sentido. Por lo tanto y como ejemplo, me remito a nuestro caso.
Nuestras principales líneas de investigación están enfocadas en el desarrollo de nuevos productos biológicos conteniendo microrganismos beneficiosos para el control de diferentes enfermedades, bioestimulantes y biofertilizantes, así como también la mejora de los actuales productos.
Estamos focalizados en estas líneas de investigación para el desarrollo de soluciones biológicas aplicadas a la agricultura por la importancia que las mismas tienen en el desarrollo de una agricultura sostenible enfocada en la preservación del medioambiente al cultivar y criar animales sin depender de pesticidas químicos tóxicos, fertilizantes sintéticos, semillas genéticamente modificadas o prácticas que degradan el suelo, el agua u otros recursos naturales. Todo esto ayuda en la protección de la salud pública pues se reduce la exposición de las personas a sustancias perjudiciales en los alimentos y el medioambiente.
¿Por qué hay esta tendencia en determinadas empresas por potenciarse en el "área Bio"?
La agricultura sostenible es un futuro que ya está aquí y no puede esperar, aunque es cierto que de momento estaremos en una etapa de transición donde tendremos que aceptar la convivencia de métodos agrícolas en los cuales, aunque no se pueda todavía eliminar del todo los productos químicos, al menos reducir y restringir su uso solo cuando sea necesario y esté justificado.
Se tiene la idea de que para llegar a esto es difícil y se necesita mucho esfuerzo para lograrlo, aunque no es del todo cierto. Definitivamente, es un reto para el sector agrícola, pues se necesita un cambio en la forma de pensar, evaluar, aplicar, etc.
Estamos ante productos biológicos, muy diferentes a los productos químicos, los cuales han tenido un desarrollo vertiginoso desde la revolución verde. Esta revolución ha supuesto una de las etapas claves en el desarrollo agrícola que mejoró la producción de alimentos a nivel mundial a partir del desarrollo de nuevas variedades, combinado con el uso masivo y extensivo de fertilizantes y pesticidas, y cuyas consecuencias estamos teniendo ahora.
Por ello, ahora es necesario cambiar la manera de hacer las cosas e ir hacia el desarrollo de productos biológicos.
Hay que considerar que los productos biológicos no funcionan de la misma manera que los químicos convencionales. Son productos tecnológicos que requieren un conocimiento técnico y un manejo bastante diferente a lo que los agricultores están acostumbrados.
En este sentido, es muy importante conocer cómo funcionan, su modo de acción, los tiempos de aplicación, etc. Esos productos tienen detrás un trabajo de investigación muy potente que debe trasmitirse al usuario final: los agricultores.
¿Es rápido el desarrollo, por ejemplo, de un producto biocontrol?
El tiempo que dura el proceso completo varía dependiendo del tipo de producto en cuestión. Para el caso que preguntas, de un producto Biocontrol puede estar entre 7 a 10 años, mientras que en el caso de otro tipo de productos biológicos como biofertilizantes o bioestimulantes seria entre 3 a 5 años.
Es interesante comentar que, a pesar de la necesidad del desarrollo de nuevos productos biológicos para la agricultura actual, los parámetros y reglas que se aplican, sobre todo en el caso de los biocontroles, son las mismas que para el caso del registro de los productos químicos, debido a que es lo que conoce el sector, los agentes reguladores y los ministerios que hacen las regulaciones. Esto debería mejorarse, pero requerirá tiempo pues es un cambio radical de pensamiento y eso cuesta sobre todo al inicio.
También es necesario destacar la importancia del paso desde los ensayos de laboratorio al campo, donde es imprescindible la experiencia y el valor del trabajo del Departamento Técnico. Este equipo de profesionales se encarga de planificar los ensayos teniendo en cuenta, por una parte, los resultados obtenidos en I+D+i y por otro, como debe ser el ensayo, los parámetros a evaluar, en qué momento deben realizarse las evaluaciones, dosis a evaluar, etc., con el objetivo final de demostrar la efectividad del producto en desarrollo.
Es importante la importancia del cliente final en la toma de decisiones. Tanto que las empresas estamos constantemente en contacto con los productores mediante los Departamentos de Marketing Técnico y Operativo, quienes trasmiten a sus empresas, las necesidades tanto del mercado como de los agricultores.
Esto, en nuestro caso y como ejemplo, permite focalizarnos en proyectos de desarrollo de nuevos productos que sean importantes para solucionar problemas reales, así como actuar en la mejora de los productos que ya posee la compañía, mejorando las necesidades actuales de mercado.
Por otra parte, hay que tener en cuenta que la empresa debe llevarlo todo a una economía de escala para optimizar su inversión. Me refiero a la importancia que tienen las instalaciones de primer nivel para el desarrollo exitoso de los proyectos en los cuales se trabaja.
Siguiendo con datos de nuestra empresa para entender este concepto, se encuentran fermentadores que nos permiten escalar a diferentes volúmenes 300, 6.000 y hasta los 16.000 litros, que nos permita tener una capacidad de producción de entre 1.606.000 a 2.420.00 de litros al año. Una centrifuga industrial con capacidad para procesar 1.000 litros a la hora, que posibilita concentrar los caldos de fermentación antes de entrar a la unidad de secado para la elaboración de productos en formato WP, y recientemente se han incorporado dos cámaras de crecimiento bajo condiciones controladas (fitotrones) que nos posibilita realizar ensayos in vivo con plantas para evaluar los resultados obtenidos a nivel de laboratorio a esta escala antes de ir a ensayos en campo.
Entendemos que estamos ante un trabajo a largo plazo, ¿Cuánto se tarda en conseguir, por ejemplo, microorganismos con capacidades agronómicas?
Por supuesto que la investigación es un trabajo a largo plazo y el tiempo total dependerá del tipo de producto a desarrollar.
En primer lugar, hay que aislar las cepas a partir de suelo o de material biológico. Posteriormente debemos evaluar sus capacidades, conocer sus características más importantes, estudiar sus condiciones de reproducción a escala de laboratorio, su viabilidad en el tiempo, caracterización de los metabolitos que produce, estudiar sus interacciones con otros microorganismos, etc., con el objetivo de poder definir su potencial para el éxito del objetivo planteado con el nuevo producto que se quiere desarrollar.
Si consideramos que la cepa es válida, entonces hay que proceder al escalado del proceso de producción, evaluar costes del proceso, realizar ensayos preliminares en condiciones de laboratorio, luego pasar a realizar ensayos in vivo con plantas bajo condiciones controladas ya sea en invernadero o cámaras de cultivo, para finalmente realizar ensayos de eficacia en campo con los cultivos agrícolas dianas para el producto en desarrollo.
La última etapa es el depósito de la cepa en un banco de colección de cepas e iniciar el registro del producto que contiene la(s) cepa(s) aisladas inicialmente.
Centrándonos ya en el tiempo que dura el proceso completo, este varía dependiendo del tipo de producto en cuestión como he avanzado: entre 7 a 10 años para un producto Biocontrol, y de 3 a 5 para productos biológicos como biofertilizantes o bioestimulantes.
Por cierto, aquí también influye si el producto en desarrollo está pensado solamente para registrarse y venderse en España y por ende en Europa, o si se va a internacionalizar, en cuyo caso hay que añadir un extra de tiempo al proceso completo.
Y por supuesto, sobre todo en el caso de los biocontroles, recordemos los métodos y plazos que se aplican a la hora de su registro, a día de hoy, los mismos que para el caso del registro de los productos químicos.
Origen de los microorganismos potenciales, su coste, rentabilidad… ¿Qué nos puede decir al respecto?
Ya hemos comentado anteriormente que hay que aislar las cepas a partir de suelo o de material biológico. Hay empresas como la nuestra, que la gran mayoría de las cepas de la colección se han aislado a partir de muestras de suelo de campos cultivados con diferentes cultivos como el tomate, lechuga, alcachofas, alfalfa, etc., situados en diversas regiones de Murcia, en Cartagena y Alicante.
Aunque la mayor parte del trabajo es investigación y experimentación, debemos reconocer que siempre hay algo de suerte en este tipo de estudios, pues nunca tienes la garantía de haber seleccionado la mejor cepa a partir de las muestras analizadas.
Respecto al coste de la investigación, dependerá del tiempo y los recursos que se dediquen a ese proyecto en particular. Es muy difícil hacer generalizaciones. Pero es cierto que durante el desarrollo de la investigación se van evaluando algunos parámetros que indican si el producto en desarrollo podrá ser o no rentable, y ahí es donde intervienen otros departamentos de la compañía para realizar esta evaluación. Por ejemplo, si al realizar los estudios de actividad biológica o eficiencia vemos que las dosis a las cuales el producto es efectivo son muy elevadas, se intentará estudiar si podemos concentrar el producto, como trabajar la formulación final para intentar disminuir las cantidades a aplicar, etc. Pero si al final esto no se puede lograr a un coste razonable, pues hay que abortar el proyecto en cuestión.
Siempre tenemos puntos de chequeo de seguir o no seguir, pues es muy importante tomar las decisiones lo antes posible. No podemos perder de vista que somos empresas y la rentabilidad, como es lógico, es uno de los parámetros importantes. Si no hay rentabilidad, la sostenibilidad empresarial carece de futuro.